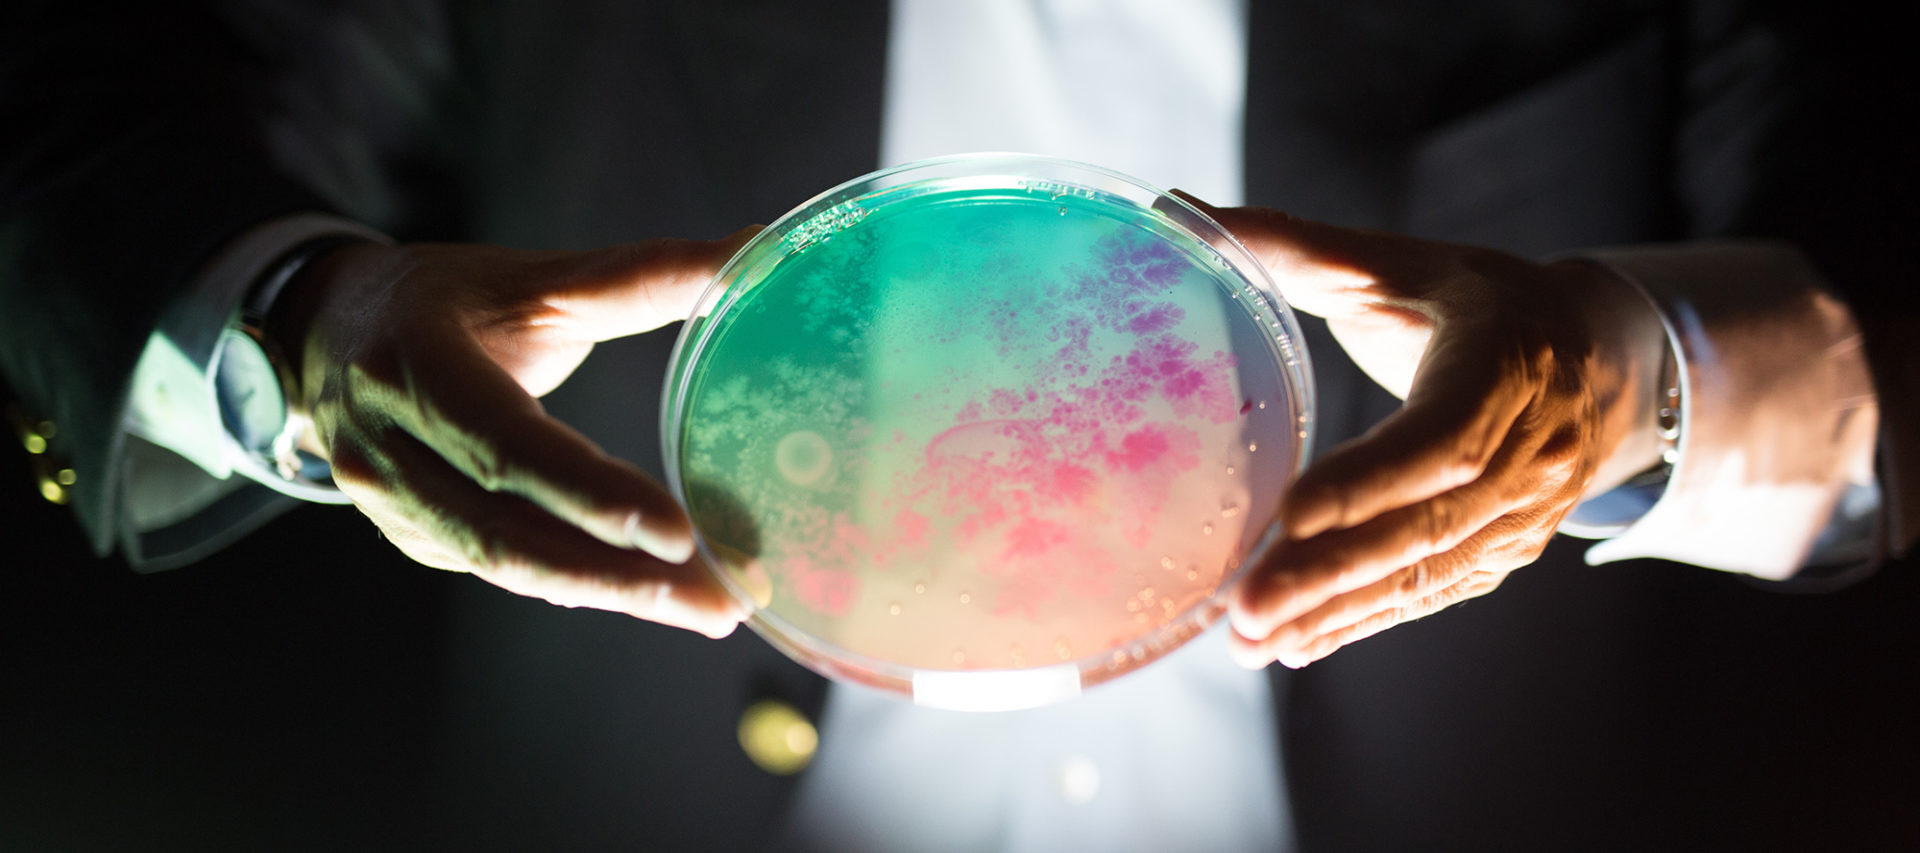

Over the past fifty years, several pivotal advances have transformed the life sciences, including the discovery of the structure of DNA, the deciphering of the genetic code, the development of recombinant DNA technology, and the mapping of the human genome. Synthetic biology is another transformative innovation that will make it possible to build living machines from off-the-shelf chemical ingredients, employing many of the same strategies that electrical engineers use to make computer chips [1]. Drawing upon a set of powerful techniques for the automated synthesis of DNA molecules and their assembly into genes and microbial genomes, synthetic biology envisions the redesign of natural biological systems for greater efficiency, as well as the construction of functional “genetic circuits” and metabolic pathways for practical purposes.
In Memoriam
The New Atlantis notes with great sadness the passing of our contributor Jonathan B. Tucker. An esteemed and prolific expert in nonproliferation policy, he was described by a close colleague as a “humble giant” of his field.
Read about the life and work of Jonathan B. Tucker here.

Among the potential applications of this new field is the creation of bioengineered microorganisms (and possibly other life forms) that can produce pharmaceuticals, detect toxic chemicals, break down pollutants, repair defective genes, destroy cancer cells, and generate hydrogen for the post-petroleum economy. Although synthetic biology is chiefly an engineering discipline, the ability to design and construct simplified biological systems offers life scientists a useful way to test their understanding of the complex functional networks of genes and biomolecules that mediate life processes [2, 3].
Today, synthetic biology is at roughly the same level of development as molecular genetics was in the mid- to late 1970s, some five years after the invention of recombinant-DNA technology. In June 2004, the first international conference devoted to the new field, “Synthetic Biology 1.0,” was held at the Massachusetts Institute of Technology (M.I.T.). The organizers claimed to have “brought together, for the first time, researchers who are working to: (1) design and build biological parts, devices, and integrated biological systems, (2) develop technologies that enable such work, and (3) place this scientific and engineering research within its current and future social context” [4]. In addition to technical presentations, policy analysts addressed the security, safety, and ethical issues associated with synthetic biology [5, 6]. The second international conference, “Synthetic Biology 2.0,” is scheduled for May 20-22, 2006, at the University of California, Berkeley [7]. Meanwhile, at M.I.T. and several other universities, synthetic biology has become a powerful catalyst for interdisciplinary research and teaching that bridges the life sciences and engineering, attracting the interest of undergraduates, graduate students, and faculty members from a wide variety of fields [8, 9].
Many of the enabling technologies for synthetic biology have existed for several years. The metabolic engineering of bacteria for natural product synthesis was first achieved in the early 1970s, and engineered bacterial plasmids for biotechnology were developed during the 1980s. Genetically modified organisms with relatively sophisticated systems for gene expression and containment have been around for nearly as long. The main difference between genetic engineering and synthetic biology is that whereas the former involves the transfer of individual genes from one species to another, the latter envisions the assembly of novel microbial genomes from a set of standardized genetic parts. These components may be natural genes that are being applied for a new purpose, natural genes that have been redesigned to function more efficiently, or artificial genes that have been designed and synthesized from scratch.
Although much of the current work on synthetic biology is taking place in the United States, research groups are also active in Europe, Israel, and Japan, and the technology will surely spread to other countries. Over the next decade, synthetic biology is likely to enter a phase of exponential growth. Already, leading U.S. practitioners have founded three private companies to commercialize the technology: Codon Devices of Cambridge, Massachusetts; Amyris Biotechnologies of Emeryville, California; and Synthetic Genomics of Rockville, Maryland [10].
If the history of molecular biology is any guide, synthetic biology research will generate a vast amount of new information about life processes — from the role of specific genes to the metabolism of whole organisms — as well as numerous applications in medicine, agriculture, industry, bioremediation, and energy. And as with any powerful new technology, synthetic biology is likely to create new risks for society, including possible unintended harmful consequences for human health or the environment, or deliberate misuse for hostile purposes. To gauge and plan for those risks, we need to understand the current status of research and the possible directions of future developments in the field.
Today, synthetic biology encompasses several different engineering strategies, including genome design and construction, applied protein design, natural product synthesis, and the construction of functional genetic circuits in cells and microorganisms. Each of these subfields is worth considering briefly.
Genome Design and Construction. One goal of synthetic biology is to “redesign” the genomes of existing microbes to make them more efficient or program them to carry out new functions. In 2005, for example, Leon Y. Chan and his co-workers at M.I.T. simplified the genome of a bacteriophage (a virus that attacks bacteria but is harmless to humans) called T7 by separating overlapping genes and editing out redundant DNA sequences to facilitate future modifications [11]. In addition, a group at the J. Craig Venter Institute in Rockville, Maryland is currently redesigning the bacterium Mycoplasma genitalium, which has the smallest known bacterial genome (482 protein-coding genes, 43 RNA genes) yet possesses all of the biochemical machinery needed to metabolize, grow, and reproduce. The Venter Institute group is striving to develop a synthetic version of the M. genitalium genome that has been stripped down to the absolute minimum number of genes required to support independent life [12]. The goal of this “minimum genome project” is to build a simplified microbial platform to which new genes can be added, creating synthetic organisms with known characteristics and functionality.
“Synthetic genomics” refers to the set of technologies that makes it possible to construct any specified gene (or full genome) from short strands of synthetic DNA called “oligonucleotides,” which are produced chemically and are generally between 50 and 100 base-pairs in length. In August 2002, Eckard Wimmer, a virologist at the State University of New York at Stonybrook, announced that over a period of several months his research team had assembled live, infectious poliovirus from customized oligonucleotides mail-ordered from a commercial supplier, using a map of the viral genome available on the Internet [13]. In 2003, Hamilton Smith and his colleagues at the Venter Institute developed a faster method for genome assembly, using synthetic oligonucleotides to construct a bacteriophage called φX174 (containing 5,386 DNA base-pairs) in only two weeks [14]. Most recently, in 2005, scientists at the U.S. Centers for Disease Control and Prevention synthesized the so-called Spanish influenza virus which was responsible for the 1918-19 flu pandemic that killed between 50 million and 100 million people worldwide [15, 16].
In the near future, synthetic genomics technology should make it possible to recreate any existing virus for which the complete DNA sequence is known [17]. At the same time, the advent of high-throughput DNA synthesis machines will cause the associated costs to drop precipitously, continuing the existing trend. In the year 2000, the price of custom oligonucleotides was about $10 per DNA base-pair; by early 2005, Blue Heron Biotechnology of Bothell, Washington was charging only $2 per base-pair (discounted to $1.60 for new customers) [18]. Over the next five years, the cost of synthetic DNA is expected to drop to about 10 cents per base-pair or even less, according to a recent report from the National Research Council and the Institute of Medicine [19]. In December 2004, George M. Church of Harvard Medical School and Xiaolian Gio of the University of Houston announced that they had invented a new “multiplex” DNA synthesis technique that Church claims will eventually reduce the cost of DNA synthesis to 20,000 base-pairs per dollar [20, 21]. If his prediction is borne out, it will transform the economics of genome synthesis.
Applied Protein Design. In the early 1980s, Kevin Ulmer of Genex Corporation conceived the idea of systematically altering the genes that code for certain proteins to achieve desired modifications in protein stability and function [22]. Since then, protein-engineering technology has been applied to develop enzymes that have improved catalytic efficiency or altered substrate specificity, or that can tolerate high temperatures and acidity levels. Today, engineered enzymes are utilized in laundry detergents and in various industrial processes. Another approach to protein engineering involves going beyond the repertoire of the 20 amino-acid building blocks found in nature. For example, a team of chemists headed by Peter G. Schultz at Lawrence Berkeley National Laboratory has expanded the genetic code to specify unnatural amino acids, which can be substituted into proteins to modify their stability as well as their catalytic and binding properties [23]. This technique has made it possible to design protein-based drugs that can resist rapid degradation in the body [24].
Natural Product Synthesis. Recombinant-DNA technology has long permitted the replication of single genes in plasmids (small loops of bacterial DNA), a technique known as “molecular cloning,” followed by the expression of the encoded proteins in bacteria or yeast cells. Useful proteins such as human insulin can be produced cheaply with this technique. Now, with the advent of synthetic biology, scientists are engineering microbes to perform complex multi-step syntheses of natural products by assembling “cassettes” of animal or plant genes that code for all of the enzymes in a synthetic pathway.
For example, Jay Keasling, a professor of chemical engineering at the University of California, Berkeley, is using synthetic-biology techniques to program yeast cells to manufacture the immediate precursor of the drug artemisinin, a natural product that is highly effective in treating malaria. At present, this compound must be extracted chemically from the sweet wormwood plant, an annual indigenous to China and Vietnam. The extraction of artemisinin is difficult and expensive, however, reducing its availability and affordability in developing countries. Keasling’s group is trying to reduce the cost of the drug by engineering a metabolic pathway for the synthesis of its immediate precursor, artemisinic acid, in yeast [25, 26].
Thus far, the Berkeley researchers have assembled a cassette of several genes from sweet wormwood that code for the series of enzymes needed to make artemisinic acid, and inserted this cassette into baker’s yeast (Saccharomyces cerevisiae). The scientists are now “tuning” the expression levels of each gene so that the entire multi-enzyme pathway functions efficiently. This task is far more complex than traditional experiments involving the cloning and expression of individual genes. Once the engineered yeast cells have been coaxed into producing high yields of the artemisinin precursor, it should be possible to manufacture this compound cheaply and in large quantities by fermentation, a process similar to brewing beer [27]. The same approach could be used to mass-produce other drugs that are currently available in limited quantities from natural sources, such as the anti-cancer drug taxol and the anti-HIV compound prostratin.
Creation of Standardized Biological Parts and Circuits. Perhaps the most ambitious subfield of synthetic biology involves efforts to develop a “tool box” of standardized genetic parts with known performance characteristics — analogous to the transistors, capacitors, and resistors used in electronic circuits — from which bioengineers can build functional devices and, someday, synthetic microorganisms [28].
The Synthetic Biology Working Group at M.I.T. is attempting to turn this concept into a reality by developing a comprehensive set of genetic building blocks, along with standards for characterizing their behavior and the conditions that support their use. In the summer of 2004, the group established a Registry of Standard Biological Parts [29]. The registry is made up of components called “BioBricks,” short pieces of DNA that constitute or encode functional genetic elements [30]. Examples of BioBricks are a “promoter” sequence that initiates the transcription of DNA into messenger RNA, a “terminator” sequence that halts RNA transcription, a “repressor” gene that encodes a protein that blocks the transcription of another gene, a ribosome-binding site that initiates protein synthesis, and a “reporter” gene that encodes a fluorescent jellyfish protein, causing cells to glow green when viewed through a fluorescence microscope [31]. A BioBrick must have a genetic structure that enables it to send and receive standard biochemical signals and to be cut and pasted into a linear sequence of other BioBricks, in a manner analogous to the pieces in a Lego set [32].
As of early April 2006, the BioBricks registry contained 167 basic parts, including sensors, actuators, input and output devices, and regulatory elements. Also included in the registry were 421 composite parts, and an additional 50 parts were being synthesized or assembled [33]. Emulating the approach employed by open-source software developers, the M.I.T. group has placed the registry on a public website (http://parts.mit.edu/) and invited all interested researchers to comment on and contribute to it. The ultimate goal of this effort is to develop a methodology for the assembly of BioBricks into circuits with practical applications, while eliminating unintended or parasitic interactions that could compromise the characterized function of the parts [34].
To date, BioBricks have been assembled into a few simple genetic circuits. One such circuit renders a film of bacteria sensitive to light, so that it can capture an image like a photographic negative [35, 36]. In other experiments, BioBricks have been combined into devices that function as logic gates and perform simple Boolean operations, such as AND, OR, NOT, NAND, and NOR. For example, an AND operator generates an output signal when it gets a biochemical signal from both of its inputs; an OR operator generates a signal if it gets a signal from either input; and a NOT operator (or inverter) converts a weak signal into a strong one, and vice versa. The long-term goal of this work is to convert bioengineered cells into tiny programmable computers, so that it will be possible to direct their operation by means of chemical signals or light [37].
Although synthetic biologists have accomplished a great deal in a short time, major obstacles remain to be overcome before the practical applications of the technology can be realized. One problem is that the behavior of bioengineered systems remains “noisy” and unpredictable. Genetic circuits also tend to mutate rapidly and become nonfunctional. Drew Endy of M.I.T., one of the pioneers in the field, believes that synthetic biology will not achieve its potential until scientists can predict accurately how a new genetic circuit will behave inside a living cell. He argues that the engineering of biological systems remains expensive, unreliable, and ad hoc because scientists do not understand the molecular processes of cells well enough to manipulate them reliably [38].
Writing in Nature in late 2005, Endy suggested three strategies for overcoming these obstacles. The first, standardization, refers to the “promulgation of standards that support the definition, description and characterization of the basic biological parts, as well as standard conditions that support the use of parts in combination and overall system operation.” The M.I.T. Registry of Standard Biological Parts is a first step toward that end. The second, decoupling, is the effort to “separate a complicated problem into many simpler problems that can be worked on independently, such that the resulting work can eventually be combined to produce a functioning whole.” Finally, abstraction is a method for organizing information describing biological functions into “hierarchies” that operate at different levels of complexity. Following these strategies, Endy writes, “would help make routine the engineering of synthetic biological systems that behave as expected” [39].
An assessment of the risks involved in synthetic biology research must begin with two obvious points. First, because engineered microorganisms are self-replicating and capable of evolution, they belong in a different risk category than toxic chemicals or radioactive materials. Second, some of the risks of synthetic biology are simply indefinable at present — that is, there may be risks that we cannot anticipate with any degree of precision at this early stage in the development of the field.
That said, we can use history as a guide — particularly the history of recombinant DNA technology — to discern three main areas of risk in synthetic biology. First, synthetic microorganisms might escape from a research laboratory or containment facility, proliferate out of control, and cause environmental damage or threaten public health. Second, a synthetic microorganism developed for some applied purpose might cause harmful side effects after being deliberately released into the open environment. Third, outlaw states, terrorist organizations, or individuals might exploit synthetic biology for hostile or malicious purposes.
The history of the risks and safeguards involved in recombinant DNA research, which involves the cutting and splicing of genes from different species, is instructive for understanding the risks associated with synthetic biology. The first people to voice concerns about the potential risks of recombinant DNA research were the scientists doing the work. During the summer of 1975, the leading investigators in the field met at the Asilomar Conference Center in Pacific Grove, California, to discuss the hazards associated with the new technology. They concluded that although most gene transfers posed a low level of risk, a few types of experiments, such as the insertion of toxin genes and virulence factors into bacteria, could entail significant dangers. In response, the National Institutes of Health (NIH) established a Recombinant DNA Advisory Committee (RAC) to develop biosafety guidelines and a process for institutional oversight that would apply to all NIH-funded research projects.
Under the NIH Guidelines, which were adopted in 1976, the most dangerous experiments were banned and others were subjected to a thorough risk assessment. The guidelines specify the level of laboratory biocontainment required for different types of gene-transfer experiments [40]. Many scientists considered the NIH Guidelines overly restrictive when they were first introduced, but over the past thirty years, the guidelines have gradually evolved in response to experience: Because of the excellent safety record of gene-splicing research and development, the RAC has since downgraded the biosafety requirements for most types of recombinant DNA experiments.
Despite the fact that no accidental release of a genetically-engineered microorganism (GEM) from a laboratory has been reported, it is possible that such releases have occurred but that the effects were so unremarkable that they remained undetected. GEMs generally appear to be less “fit” than their natural counterparts and hence would probably die off rapidly in the environment. Nevertheless, given their potential to replicate and evolve, special precautions are warranted. To reduce the probability that GEMs could proliferate outside a containment facility, the NIH Guidelines require that scientists build safeguards into the host microbes that receive foreign DNA. For example, researchers have developed bacterial strains that are metabolically deficient and thus require special nutrients that are not available in nature, so that the bacteria can survive and propagate only under artificial laboratory conditions [41].
The main lesson for synthetic biology from the regulation of recombinant DNA research concerns the extent of the researcher’s familiarity with the host microbe that is being genetically modified. Because the microorganisms used for genetic engineering, such as the bacterium E. coli and the yeast S. cerevisiae, are well understood by scientists, the transfer of one or two foreign genes is unlikely to change the characteristics of the host in a dramatic, unpredictable way.
To what extent would the risks associated with a synthetic microorganism differ from those of a genetically engineered one? At least for the near future, the vast majority of synthetic biological systems will be engineered by transferring small genetic circuits into a well-understood bacterial host, limiting the level of risk. A decade from now, however, synthetic genomes may be assembled from BioBricks that have been redesigned or are entirely artificial, having been created de novo. If a synthetic microorganism is built by combining these genetic elements in a new way, it will lack a clear genetic pedigree and could have “emergent properties” arising from the complex interactions of its constituent genes. Accordingly, the risks attending the accidental release of such an organism from the laboratory would be extremely difficult to assess in advance, including its possible spread into new ecological niches and the evolution of novel and potentially harmful characteristics.
During the process of laboratory research, animal testing in a contained facility may suggest whether or not a synthetic microorganism is pathogenic. Nevertheless, no animal model can predict infallibly how a novel microbe will behave in a human host, and there is no reliable way to measure its possible impact on complex ecosystems. It is also unclear whether or not the standard techniques used to prevent GEMs from proliferating outside the laboratory will be effective for synthetic microbes [42]. As a result, future research involving the creation of synthetic microorganisms will pose major challenges for assessing and managing biosafety risks. It is not too early to begin thinking about this problem, which is likely to be quite difficult to solve.
To the extent that synthetic microorganisms lack a natural genetic pedigree, regulators may insist on developing new biosafety guidelines or regulations to prevent their accidental release into the environment. At present, it is unclear if these rules would resemble the NIH Guidelines or would be specific to synthetic biology. One approach to reducing the possible risks associated with synthetic microorganisms would be to ensure that they are inherently incapable of surviving and replicating outside the laboratory. For example, synthetic bacteria might be endowed with a redesigned genetic code and unnatural amino acids so that even if the engineered genes were taken up by natural cells or viruses, they could not be expressed. Scientists may also build into a synthetic microbe a “self-destruct” mechanism that is triggered by a high density of microorganisms, a specified number of cell divisions, or an external chemical signal [43]. Nevertheless, such built-in control mechanisms may not be foolproof. If, for example, a synthetic microorganism is accidentally released into the environment, it might conceivably mutate or exchange genetic material with indigenous natural microorganisms in a way that makes the built-in controls ineffectual.
Given these uncertainties, it would be prudent to adopt the “precautionary principle” and treat synthetic microorganisms as dangerous until proven harmless. According to this approach, all organisms containing assemblies of BioBricks would have to be studied under a high level of biocontainment (Biosafety Level 3 or even 4) until their safety could be demonstrated in a definitive manner. As George Church argued in Nature in 2005, “Learning from gene therapy, we should imagine worst-case scenarios and protect against them. For example, full physical isolation and confined lab experiments on human and agricultural pathogens should continue until we have data on a greater number of potential consequences — ecological and medical — of engineering such systems” [44].
By definition, some of the proposed applications of synthetic biology, such as biosensing, agriculture, and bioremediation (for example, cleaning up soil contaminated with toxic chemicals), would involve the use of synthetic microorganisms in the open environment. To date, only a small number of GEMs have been developed for applications outside of the laboratory or containment facility. According to the U.S. Department of Agriculture’s Animal and Plant Health Inspection Service, GEMs may be developed and used for agricultural purposes, such as enriching soil, without a permit if the “recipient microorganisms…are not plant pests and…result from the addition of genetic material containing only noncoding regulatory regions” [45].
With respect to bioremediation, the Environmental Protection Agency requires a stringent risk assessment before it will approve the release into the environment of a GEM that can break down specific pollutants. Although few GEMs have been developed for this purpose, including genetically modified strains of the common soil bacterium Pseudomonas putida, they have been tested only in the laboratory and in one field test carried out in 1996 under tightly controlled conditions. In that experiment, Gary Sayler and his colleagues at the University of Tennessee’s Center for Environmental Biotechnology used soil lysimeters, steel-lined tanks measuring eight feet in diameter and filled with a large volume of soil, to monitor bioengineered bacteria as they degraded a toxic chemical [46]. Because of the uncertain ecological impacts of conducting such experiments in the open environment, however, no GEMs developed for bioremediation are currently in the regulatory pipeline.
Theoretically, three types of negative effects could result from releasing a synthetic microorganism into the environment. First, the organism could disrupt local biota or fauna through competition or infection that, in the worst case, could lead to the extinction of one or more wild species. Second, once a synthetic organism has successfully colonized a locale, it might become endemic and thus impossible to eliminate. Third, the synthetic organism might damage or disrupt some aspect of the habitat into which it was introduced, upsetting the natural balance and leading to the degradation or destruction of the local environment.
U.S. government agencies, foreign governments, and intergovernmental organizations all take different approaches to assessing the risks associated with the deliberate release of a GEM into the open environment. Generally speaking, though, an inventor seeking permission to release a GEM must answer five questions in detail:
Based on the answers to these five questions, a regulatory agency can perform an objective risk assessment of the proposed release of a GEM. It is by no means clear, however, that one could answer these questions for a synthetic microorganism. Because a microbe constructed from BioBricks would not contain genetic material transferred from another species, Questions 1 and 2 are not relevant as stated, although the “familiarity” criterion is key. Could the inventor of a synthetic microorganism be said to be truly “familiar” with it? On the one hand, the inventor would know every BioBrick making up the genetic circuitry of the organism. On the other hand, he or she would have little understanding of the organism’s emergent properties, including how the synthetic microbe will interact with other living entities after its release into the ecosystem. Assuming that the answer to Question 3 (familiarity with the environment) is “yes,” the answer to Question 4 must inevitably be “no” when dealing with self-replicating synthetic microorganisms. Thus, the answer to Question 5 is critical. Because of a lack of empirical evidence, the inventor of a synthetic microorganism could not predict the effects of its release on human health and the environment with any degree of confidence.
Given these uncertainties, scientists seeking to develop synthetic microorganisms for applications outside a containment facility will need to develop new ways to assess their impact on the environment. One approach is to perform systematic testing in an experimental ecosystem that has been designed and constructed by biologists to analyze ecological dynamics. There are two types of model ecosystems: a “microcosm,” which varies in size from a few milliliters to 15 cubic meters, and a “mesocosm,” which is larger than 15 cubic meters [48]. These model systems consist of elements of a natural ecosystem, such as soil, vegetation, lake water, and sediment, which are brought together in a container such as an aquarium, an earth-lined pond, or a PVC tank, and allowed to equilibrate. (The soil lysimeter described above is a type of mesocosm.) Ideally, a model ecosystem should be sufficiently realistic and reproducible to serve as a bridge between the laboratory and a field test in the open environment.
Microcosm and mesocosm studies have been useful in several environmental applications, such as measuring the stress placed on various types of ecosystems by synthetic chemicals, natural microorganisms, and GEMs. In addition, model ecosystems have served to estimate the extent to which the foreign genetic material introduced into a GEM can be transferred to other organisms or can persist by itself in the environment [49]. However, some scientists and regulatory agencies have rejected data from microcosm and mesocosm studies because of a lack of consistency in the way the experiments were performed and the results interpreted. With this problem in mind, it may be necessary for the synthetic biology community to develop a standardized methodology for testing the environmental impact of its inventions.
One of the lessons from the history of recombinant DNA research is that the products made by genetically engineered microbes are no more hazardous than those manufactured by more traditional methods. Thus, for drugs and proteins made by synthetic microorganisms (such as the artemisinin precursor produced in yeast), U.S. regulators will probably focus on the safety of the final product rather than the method of production. In contrast, countries in Western Europe and other parts of the world have taken a more restrictive approach to genetically modified foods and may likewise be inclined to discriminate against drugs and other items manufactured by synthetic microorganisms.
The 1972 Biological and Toxin Weapons Convention (BWC) bans the development, production, stockpiling, and transfer of “microbial or other biological agents, or toxins whatever their origin or method of production, of types and in quantities that have no justification for prophylactic, protective or other peaceful purposes” [50]. Thus, the BWC implicitly prohibits the synthesis of known or novel microorganisms for hostile purposes. Moreover, if synthetic organisms were designed to produce toxins, then the development and production of these poisons for weapons purposes would be prohibited by both the BWC and the 1993 Chemical Weapons Convention [51]. Nevertheless, because the BWC has not been signed and ratified by every country, lacks formal verification mechanisms, and does not bind non-state entities such as terrorist organizations, it does little to prevent the deliberate misuse of synthetic biology for hostile purposes.
One potential misuse of synthetic biology would be to recreate known pathogens (such as the Ebola virus) in the laboratory as a means of circumventing the legal and physical controls on access to “select agents” that pose a bioterrorism risk. Indeed, the feasibility of assembling an entire, infectious viral genome from a set of synthetic oligonucleotides has already been demonstrated for poliovirus and the Spanish influenza virus [52]. As DNA synthesis technology improves, the assembly of even larger viruses (such as variola, the causative agent of smallpox) may eventually become feasible. J. Craig Venter noted, in testimony before a Senate subcommittee in 2005, that although a bioterrorist could use synthetic genomics to make a pathogenic virus, “the number of pathogens that can be synthesized today is small and limited to those with sequenced genomes. And for many of these the DNA is not infective on its own and poses little actual threat. Our concern is what the technology might enable decades from now” [53].
Indeed, projecting a decade or more into the future, some analysts have made dire predictions about the potential misuse of synthetic biology techniques for the development of more lethal or militarily effective biological warfare agents. In November 2003, for example, an expert panel set up by the U.S. Central Intelligence Agency released a short white paper that concludes, “Growing understanding of the complex biochemical pathways that underlie life processes has the potential to enable a class of new, more virulent biological agents engineered to attack distinct biochemical pathways and elicit specific effects” [54]. This unclassified report provides no details concerning the expertise, equipment, and facilities that would be required to develop such engineered biowarfare agents, nor a time estimate for how long the development process might take.
In a similar effort at prediction, Mark Wheelis, a microbiologist at the University of California, Davis, painted a frightening picture of synthetic biology twenty years or more into the future. Among his predictions in a 2004 Arms Control Today article: “Living synthetic cells will likely be made in the next decade; synthetic pathogens more effective than wild or genetically engineered natural pathogens will be possible sometime thereafter….Such synthetic cellular pathogens could be designed to be contagious or noncontagious, lethal or disabling, acute or persistent” [55].
How should one assess these predictions about the potential misuse of synthetic biology for hostile purposes? At present, the primary threat of misuse appears to come from state-level biological warfare programs, some of which probably exploit advanced molecular biology techniques. It is known that Soviet weapons scientists conducted genetic engineering research with dangerous pathogens, such as those that cause anthrax, plague, and tularemia [56]. Could scientists possessing this expertise employ synthetic biology to design and construct an entirely artificial pathogen that is significantly more deadly and robust than those that already exist in nature?
In fact, such a scenario is extremely unlikely. To create such an artificial pathogen, a capable synthetic biologist would need to assemble complexes of genes that, working in unison, enable a microbe to infect a human host and cause illness and death. Designing the organism to be contagious, or capable of spreading from person to person, would be even more difficult. A synthetic pathogen would also have to be equipped with mechanisms to block the immunological defenses of the host, characteristics that natural pathogens have acquired over eons of evolution. Given these daunting technical obstacles, the threat of a synthetic “super-pathogen” appears exaggerated, at least for the foreseeable future.
The most likely misapplication of synthetic biology for hostile purposes involves the recreation of known pathogenic viruses in the laboratory. Contrary to popular belief, however, a biological weapon is not merely an infectious agent but a complex system consisting of (1) a supply of pathogen, either produced in the form of a wet slurry or dried and milled into a dry powder; (2) a complex “formulation” of chemical additives that is mixed with the agent to stabilize it and preserve its infectivity and virulence during storage; (3) a container to store and transport the formulated agent; and (4) an efficient dispersal mechanism to disseminate the formulated agent as a fine-particle aerosol that can infect the targeted personnel through the lungs. Finally, the aerosol cloud must be released under optimal atmospheric and meteorological conditions if it is to inflict casualties over a large area. Given the major technical hurdles associated with weaponization and delivery, the advent of synthetic biology is unlikely to cause a dramatic increase in the threat of bioterrorism. [57]
Nevertheless, two possible scenarios for the deliberate misuse of synthetic biology provide some grounds for concern. The first involves a “lone operator,” such as a highly trained molecular biologist who develops an obsessive grudge against certain individuals or groups (or society as a whole). If Theodore Kaczynski, the “Unabomber,” had been a microbiologist instead of a mathematician, he might have fit this profile; perhaps the perpetrator of the 2001 anthrax-letter attacks does fit it. So-called “lone wolf” terrorists have proven very innovative and difficult to locate; if armed with a weapon of mass destruction, such a lone operator could cause as much damage as an organized group.
How likely is this lone operator scenario? In any large population of professionals, a small minority may be prepared to use their skills for illicit purposes. Thus, the growing synthetic biology community can be expected to include a few individuals with access to laboratory equipment and supplies who are highly intelligent and well-trained but also deeply disgruntled, have sociopathic tendencies, or wish to prove something to the world. Such an individual might work alone to synthesize a natural pathogen or one incorporating foreign virulence factors. Possible motivations might include inflicting harm on a former or current employer, lover, or a hated ethnic group, profiting from blackmail, eliminating rivals, obtaining perverse pleasure from overcoming technical challenges, or demonstrating scientific and technical superiority.
A lone operator with expertise in synthetic biology would also have a number of characteristics that would pose special difficulties for those seeking to prevent or defend against terrorist attacks. He would not be restricted in his actions by group decision-making and could purchase dual-use equipment and materials for a DNA synthesis laboratory, none of which would provide an obvious tip-off of illicit activity. And precisely because he would be working solo, a lone operator would be unlikely to be discovered by the intelligence community or the police before he strikes [58].
The pool of people capable of misusing synthetic biology is currently limited to the small number of undergraduates, graduate students, and senior scientists who constitute the research community — probably fewer than 500 people in early 2006. In the future, however, the number of capable individuals will grow rapidly as researchers are drawn to this exciting and dynamic field.
The second scenario of concern is that of a “biohacker,” an individual who does not necessarily have malicious intent but seeks to create bioengineered organisms out of curiosity or to demonstrate his technical prowess — a common motivation of many designers of computer viruses [59]. The reagents and tools used in synthetic biology will eventually be converted into commercial kits, making it easier for biohackers to acquire them. Moreover, as synthetic-biology training becomes increasingly available to students at the college and possibly even high-school levels, a “hacker culture” may emerge, increasing the risk of reckless or malevolent experimentation.
The risks of inadvertent or deliberate harm from synthetic biology clearly warrant a policy response. Although some scientists consider it premature to consider ways of regulating the field at such an early stage in its development, prudence suggests that it is better to start addressing the problem early, rather than having to react after an unanticipated mishap or disaster has provoked a political backlash.
Returning to the historical record, more than three decades of experience have shown that the NIH Guidelines governing recombinant DNA research have functioned reasonably well to protect scientists and the public from potential hazards, while allowing science to advance relatively unhindered. The main concerns about the possible hazards from GEMs have shifted over the years from laboratory research to field testing and use. Nevertheless, public suspicions persist, particularly in Western Europe, about the safety of genetically engineered foods. It is therefore important to consider how the public will respond to the commercial applications of synthetic biology. Although the first such products will not appear for several years, one can imagine the impact of a news report that a team of scientists has created an entirely new life form that is busily replicating itself in a laboratory. Fear of the unknown, whether rational or irrational, might lead to a hasty or inappropriate response, one that unnecessarily impedes scientific progress or ineffectively protects the public good.
Yet it also seems likely that, given the difficulty of anticipating and assessing the risks associated with synthetic organisms, synthetic biology will require a new approach to regulation that differs significantly from the NIH Guidelines on recombinant DNA. Accordingly, it would be useful to bring several leading practitioners of synthetic biology together with biosafety experts, social scientists, ethicists, and legal scholars to brainstorm about reasonable approaches for the oversight and control of such research. The following elements of a regulatory regime might be considered:
Screening of oligonucleotide orders. At present, it is possible to place orders for oligonucleotides and genes over the Internet to custom supply houses, which synthesize any DNA sequence upon request and keep the transaction confidential. As University of Washington biotechnology analyst Rob Carlson has noted, oligonucleotide producers have emerged in several countries around the world, including nations such as China and Iran [60]. A U.S. gene-synthesis company, Blue Heron Biotechnology, voluntarily uses special software to screen all oligonucleotide and gene orders for the presence of DNA sequences from “select agents” of bioterrorism concern. When such a sequence is detected, the request is denied, although there is currently no procedure for reporting such incidents to U.S. government authorities [61]. Nevertheless, suppliers are currently under no legal obligation to screen their orders, and because many clients value confidentiality, companies might put themselves at a competitive disadvantage by doing so. There are two possible solutions to this problem. First, Congress could pass a law requiring U.S. suppliers to screen all oligonucleotide and gene orders for pathogenic DNA sequences. Alternatively, suppliers could agree among themselves to screen orders voluntarily, or legitimate researchers could choose to patronize only those companies that do so. Because the trade involves several countries, however, an effective regulatory regime would have to be international in scope.
Ecological modeling of synthetic microorganisms. Given the difficulty of predicting the risks to public health and the environment posed by synthetic microorganisms, it will be essential to study the ecological behavior of such agents in enclosed microcosms or mesocosms that model as accurately as possible the ecosystem into which the organism will be released. Such studies should examine the extent to which the genetic material from a synthetic microorganism is transferred to other organisms or persists intact in the environment. In the event that the uncertainties associated with the liberation of synthetic microbes prove to be irreducible, it may be necessary to ban all uses in the open environment until a robust risk assessment can be conducted for each proposed application.
During Covid, The New Atlantis has offered an independent alternative. In this unsettled moment, we need your help to continue.

Oversight of research. Research in synthetic biology may generate “dual-use” findings that could enable proliferators or terrorists to develop biological warfare agents that are more lethal, easier to manufacture, or of greater military utility than today’s bioweapons. In rare cases, it may be necessary to halt a proposed research project at the funding stage or, if unexpectedly sensitive results emerge that could threaten public health or national security, to place constraints on publication [62]. Relevant guidelines for the oversight of “dual-use” research are currently being developed by the U.S. government’s National Scientific Advisory Board for Biosecurity and should eventually be “harmonized” internationally [63].
Public outreach and education. Because of the potential for intense controversy surrounding synthetic biology, public outreach and education are needed even at this early stage in the field’s development [64]. Although it is often difficult to persuade scientists to leave the laboratory for even a few hours to participate in a public discussion of their work and its implications for society, such efforts should be encouraged because they generate good will and may help to prevent a future political backlash that could cripple the emerging field of synthetic biology.
At present, synthetic biology’s myriad implications can be glimpsed only dimly. The field clearly has the potential to bring about epochal changes in medicine, agriculture, industry, ethics, and politics, and a few decades from now it may have a profound influence on the definition of life, including what it means to be human. Some critics consider the idea of creating artificial organisms in the laboratory to be a frightening example of scientific hubris, evocative of Faust or Dr. Frankenstein. Yet given the momentum and international character of research in synthetic biology, it is already too late to impose a moratorium, if indeed one was ever contemplated.
Instead, practitioners and policy analysts should begin a wide-ranging debate about how best to guide synthetic biology in a safe and socially useful direction without smothering it in the cradle. In so doing, it will be useful to hark back to the enlightened group of biologists who met at Asilomar in 1975 to discuss another exciting new technology — recombinant DNA — that appeared to offer great benefits and unknown dangers. Their deliberations led to the decision to proceed with caution, subjecting potentially dangerous experiments to careful risk assessment and oversight. That approach, which has since proven remarkably successful, bears emulating today. In the process, however, we may discover that synthetic biology poses novel regulatory and ethical challenges as scientists learn how to manipulate the most basic elements of living systems.
1. Synthetic Biology Research Community, online at SyntheticBiology.org (accessed December 30, 2005).
2. Dan Ferber, “Microbes made to order,” Science, vol. 303, no. 5655 (January 9, 2004), pp. 158-161.3. Institute of Medicine and National Research Council, Globalization, Biosecurity, and the Future of the Life Sciences (Washington, D.C.: National Academies Press, 2006), p. 135.4. Synthetic Biology Research Community, “Synthetic Biology 1.0: The first international meeting on synthetic biology,” held at MIT on June 10-12, 2004, http://www.syntheticbiology.org/Synthetic_Biology_1.0.html (accessed January 21, 2006).5. George Poste, “Synthetic biology: charting rational public policies for the oversight and regulation of vanguard technologies,” June 11, 2004, http://openwetware.org/images/3/3a/SB1.0_George.Poste.pdf (accessed January 21, 2006).6. Paul Rabinow, “Assembling ethics in an ecology of ignorance,” June 11, 2004, http://openwetware.org/images/7/7a/SB1.0_Rabinow.pdf (accessed January 21, 2006).7. For information on Synthetic Biology 2.0, see http://pbd.lbl.gov/sbconf/.8. American Association for the Advancement of Science, Public Lecture Series 2005, “Synthetic biology: hardware, software, and wetware,” http://www.aaas.org/spp/dser/02_Events/Lectures/2005/02_Lecture_2005_1110.pdf (accessed December 29, 2005).9. Pamela Silver and Jeffrey Way, “Cells by Design,” The Scientist, vol. 18, no. 18 (September 27, 2004), p. 30.10. Codon Devices, http://www.codondevices.com/ (accessed January 20, 2006); Amyris Biotechnologies, http://www.amyrisbiotech.com/ (accessed January 20, 2006); Synthetic Genomics, http://www.syntheticgenomics.com/ (accessed January 20, 2006).11. Leon Y. Chan, Sriram Kosuri, and Drew Endy, “Refactoring bacteriophage T7,” Molecular Systems Biology (published online September 13, 2005).12. John I. Glass, Nacyra Assad-Garcia, Nina Alperovich, Shibu Yooseph, Matthew R. Lewis, Mahir Maruf, Clyde A. Hutchinson III, Hamilton O. Smith, and J. Craig Venter, “Essential genes of a minimal bacterium,” Proceedings of the National Academy of Sciences, vol. 103, no. 2 (January 10, 2006), pp. 425-430.13. Jeronimo Cello, Aniko V. Paul, and Eckard Wimmer, “Chemical synthesis of poliovirus cDNA: Generation of infectious virus in the absence of natural template,” Science, vol. 297, no. 5583 (August 9, 2002), pp. 1016-1018.14. Hamilton O. Smith, Clyde A. Hutchison, III, Cynthia Pfannkoch, and J. Craig Venter, “Generating a synthetic genome by whole genome assembly φX174 bacteriophage from synthetic oligonucleotides,” Proceedings of the National Academy of Sciences, vol. 100, no. 26 (December 23, 2003), pp. 15440-15445.15. Terence M. Tumpey, Christopher F. Basler, Patricia V. Aguilar, Hui Zeng, et al., “Characterization of the reconstructed 1918 Spanish influenza pandemic virus,” Science, vol. 310, no. 5745 (October 7, 2005), pp. 77-80.16. John M. Barry, “1918 Revisited: Lessons and Suggestions for Further Inquiry,” The Threat of Pandemic Influenza: Are We Ready?, Stacey L. Knobler, Alison Mack, Adel Mahmoud, Stanley M. Lemon, eds. (Washington, D.C.: National Academies Press, 2005), p. 58.17. Philip Ball, “Starting from scratch,” Nature, vol. 431, no. 7009 (October 7, 2004), pp. 624-626.18. Blue Heron Biotechnology, http://www.blueheronbio.com/ (accessed January 21, 2006).19. Institute of Medicine and National Research Council, Globalization, Biosecurity, and the Future of the Life Sciences (Washington, D.C.: National Academies Press, 2006), p. 18.20. Jingdong Tian, Hui Gong, Nijing Sheng, Xiaochuan Zhou, Erdogan Gulari, Xiolian Gao, and George Church, “Accurate multiplex gene synthesis from programmable DNA microchips,” Nature, vol. 432, no. 7020 (December 23, 2004), pp. 1050-1054.21. Nicholas Wade, “A DNA Success Raises Bioterror Concern,” New York Times, January 12, 2005, p. 17.22. Kevin M. Ulmer, “Protein engineering,” Science, vol. 219, no. 4585 (February 11, 1983), pp. 666-671.23. Lei Wang, Ansgar Brock, Brad Herberich, and Peter G. Schultz, “Expanding the genetic code of Escherichia coli,” Science, vol. 292, no. 5516 (April 20, 2001), pp. 498-500.24. Steven A. Benner and A. Michael Sismour, “Synthetic biology,” Nature Reviews Genetics, vol. 6, no. 7 (July 2005), pp. 533-543.25. Dae-Kyun Ro, Eric M. Paradise, Mario Ouellet, Karl J. Fisher, Karyn L. Newman, Jay D. Keasling, et al., “Production of the antimalarial drug precursor artemisinic acid in engineered yeast,” Nature, vol. 440, no. 7086 (April 13, 2006), pp. 940-943.26. Alan Moses, “Intelligent design: Playing with the building blocks of biology,” Berkeley Science Review, vol. 5, no. 1 (Spring 2005), pp. 34-40.27. Synthetic Biology Department, Physical Biosciences Division, Lawrence Berkeley National Laboratory, http://www.lbl.gov/synthbio.28. Jeff Hasty, David McMillen, and J. J. Collins, “Engineered gene circuits,” Nature, vol. 420, no. 6912 (November 14, 2002), pp. 224-230.29. M.I.T., Registry of Standard Biological Parts, http://parts.mit.edu/.30. Ted Greenwald, “How a Biobrick Works,” Wired (January 2005), p. 172.31. Ferber, “Microbes made to order,” op. cit., p. 159.32. Oliver Morton, “Life, Reinvented,” Wired (January 2005), pp. 168-175.33. M.I.T., Registry of Standard Biological Parts, op. cit., (accessed April 10, 2006).34. Adam Paul Arkin, personal communication to the authors, March 13, 2006.35. Anselm Levskaya, Aaron A. Chevalier, Jeffrey J. Tabor, Zachary Booth Simpson, Laura A. Lavery, Matthew Levy, Eric A. Davidson, Alexander Scouras, Andrew D. Ellington, Edward M. Marcotte, and Christopher A. Voigt, “Engineering Escherichia coli to see light,” Nature, vol. 438, no. 7067 (November 24, 2005), pp. 441-442.36. Andrew Pollack, “Custom-Made Microbes, at Your Service,” New York Times, January 17, 2006, p. F1.37. Ferber, “Microbes made to order,” op. cit., p. 160.38. Drew Endy, “Foundations for engineering biology,” Nature, vol. 438, no. 7067 (November 24, 2005), pp. 449-453.39. Ibid.40. National Institutes of Health, NIH Guidelines for Research Involving Recombinant DNA Molecules (April 2002), http://www4.od.nih.gov/oba/rac/guidelines_02/NIH_Gdlnes_lnk_2002z.pdf (accessed January 23, 2006).41. Ball, “Starting from scratch,” op. cit., p. 626.42. Dan Ferber, “Time for a synthetic biology Asilomar?” Science, vol. 303, no. 5655 (January 9, 2004), p. 159.43. Ball, “Starting from scratch,” op. cit., p. 626.44. George Church, “Let us go forth and safely multiply,” Nature, vol. 438, no. 7067 (November 24, 2005), p. 423.45. Animal and Plant Health Inspection Service, U.S. Department of Agriculture, Questions and Answers on General Regulatory Policy under 7 CFR 340, http://www.aphis.usda.gov/brs/qagen.html (accessed April 10, 2006).46. Lindsey Harrison, University of Tennessee, “Down and Dirty” (December 15, 2000), online at: http://notes.utk.edu/bio/unistudy.nsf/9eab68a4f27cc7dd85256e3600733574/6a3bb520fae9d3a485256f330050e4c2 (accessed April 10, 2006).47. Adapted from Raymond A. Zilinskas, “Analysis of the ecological risks associated with genetically engineered marine microorganisms,” in Raymond A. Zilinskas and Peter J. Balint (eds.), Genetically Engineered Marine Organisms: Environmental and Economic Risks and Benefits (New York: Kluwer Academic Publishers, 1998), pp. 95-138.48. Hans Sanderson, “Design, analysis, and interpretation of higher tier risk assessment of chemicals in aquatic microcosms,” doctoral dissertation, Roskilde University, Denmark, 2002, http://dspace.ruc.dk/bitstream/1800/834/1/Design,_Analysis,_and.pdf (accessed January 24, 2006).49. Zilinskas, “Analysis of the ecological risks associated with genetically engineered marine microorganisms,” op. cit.50. United States Arms Control and Disarmament Agency, “Convention on the Prohibition of the Development, Production and Stockpiling of Bacteriological (Biological) and Toxin Weapons and on Their Destruction,” in Arms Control and Disarmament Agreements: Text and Histories of the Negotiations, (Washington, D.C.: U.S. Arms Control and Disarmament Agency, 1996), pp. 98-104. Treaty text available online here: http://dosfan.lib.uic.edu/acda/treaties/bwc1.htm.51. United States Arms Control and Disarmament Agency, Convention on the Prohibition of the Development, Production, Stockpiling and Use of Chemical Weapons and on Their Destruction, (Washington, D.C.: U.S. Arms Control and Disarmament Agency, 1993). Treaty text available online here: http://dosfan.lib.uic.edu/acda/treaties/cwctext.htm.52. Jennifer Couzin, “Active poliovirus baked from scratch,” Science, vol. 297, no. 5579 (July 12, 2002), pp. 174-175.53. J. Craig Venter, prepared statement, Hearing Examining Twenty-First Century Biological Threats, Focusing on Dual-Purpose Preparedness Against Natural and Deliberate Microbial Threats, Subcommittee on Bioterrorism and Public Health Preparedness, Committee on Health, Education, Labor, and Pensions, United States Senate, 109th Congress, 1st sess. (May 11, 2005), p. 40.54. Central Intelligence Agency, Directorate of Intelligence, “The Darker Bioweapons Future,” November 3, 2003; http://www.fas.org/irp/cia/product/bw1103.pdf (accessed January 24, 2006).55. Mark Wheelis, “Will the New Biology Lead to New Weapons?,” Arms Control Today (July/August 2004), http://www.armscontrol.org/act/2004_07-08/Wheelis.asp (accessed January 24, 2006).56. See, for example, Ken Alibek and Stephen Handelman, Biohazard: The Chilling True Story of the Largest Covert Biological Weapons Program in the World — Told from Inside by the Man Who Ran It (New York: Random House, 1999).57. Raymond A. Zilinskas and Jonathan B. Tucker, “Limiting the Contribution of the Open Scientific Literature to the Biological Weapons Threat,” Journal of Homeland Security, December 2002, online at: http://www.homelandsecurity.org/newjournal/articles/tucker.html (accessed April 10, 2006).58. Adapted from Raymond A. Zilinskas and W. Seth Carus, Possible Terrorist Use of Modern Biotechnology Techniques (Washington, D.C.: Chemical and Biological Defense Information Analysis Center, 2002).59. Chappell Brown, “Experts worry that synthetic biology may spawn biohackers,” EE Times, June 29, 2004, online at: http://www.eet.com/at/news/showArticle. jhtml?articleID=22102744.60. Rob Carlson, “Global Distribution of Commercial DNA Foundries,” updated November 22, 2005, online at: http://synthesis.typepad.com/synthesis/2005/07/global_distribu.html.61. Ball, “Starting from scratch,” op. cit., p. 626.62. Raymond A. Zilinskas and Jonathan B. Tucker, “Limiting the Contribution of the Open Scientific Literature to the Biological Weapons Threat,” op. cit.63. For information on the NSABB, see http://www.biosecurityboard.gov/.64. Editorial, “Futures of artificial life,” Nature, vol. 431, no. 7009 (October 7, 2004), p. 613.
For the general reader:
Technical articles:
Major Scientific Papers: